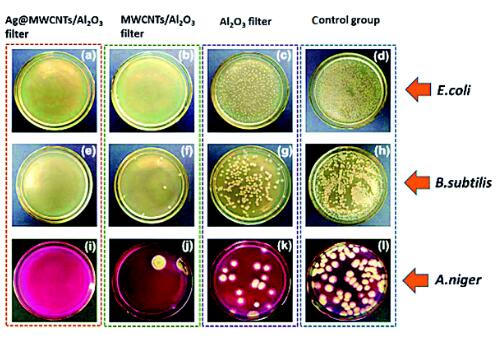
4

南京工业大学仲兆祥教授团队以多孔陶瓷材料为基体,在其颗粒堆积孔道口生长碳纳米管,随后在碳纳米管上均匀沉积纳米银颗粒,形成以微米孔道、碳纳米管和纳米催化组分构成的多层次结构膜材料。高孔隙膜基体具有三维联通的孔道结构,透气性好;纳米纤维组成的拦截网络显著提高了粉尘扩散与惯性撞击概率,且由于纤维尺度与气体分子平均自由程相当,诱导产生滑移流效应,使纤维表面的气体曳力低于非滑移流下的曳力,几乎不影响膜孔道阻力;多层次孔道结构具有较大的比表面积,是良好的催化剂载体,高度分散的纳米催化剂具有优越的催化性能,可快速降解VOCs。该膜对空气中纳米粉尘的截留率达到100%,远超过HEAP滤网国际标准(对直径为0.3微米的微粒去除率需达到99.97%),同时大幅降低过滤压降,降低了空气净化能耗,计算表明该膜具有较高的质量因子(Quality Factor),同时对革兰氏阴性菌、革兰氏阳性菌、真菌等具有良好的抑制效果,在室温下对甲醛有82.2%的一次降解率。相关研究成果发表在Nanoscale上(Nanoscale, 2017,9, 5433-5444),并被选为外封面论文。

纳米“珍珠项链”构型Ag@MWCNTs

(a) 多功能催化抑菌过滤膜的制备过程示意图;
(b-d) 多孔Al2O3陶瓷膜表面形貌;
(e-g) Ag@MWCNTs/Al2O3表面形貌;
(h) AgNPs@MWCNTs的元素分布情况。

(a)不同样品对三种细菌的动态截留性能比较;
(b) 实验室条件下,不同样品的抑菌性能比较;
(c) 真实环境下,不同样品的的动态抗菌性能比较;
(d)样品对甲醛的降解性能比较;
(e) MWCNT/Al2O3和Ag@MWCNTs/Al2O3对甲醛的降解效果对比;
(f-g) 截留率和压降的变化
(h-i) 截留率和品质因子随过滤速度的变化。
(a-d)大肠杆菌(E. coli), (e-h) 枯草芽孢杆菌(B.subtilis), 黑曲霉菌(A.niger)表征的不同样品的动态抗菌效果对比;(a,e,i)为Ag@MWCNTs/Al2O3, (b,f,j)为MWCNTs/Al2O3, (c,g,k)为Al2O3, (d,h,l)为空白样。
更多关于材料方面、材料腐蚀控制、材料科普等方面的国内外最新动态,我们网站会不断更新。希望大家一直关注中国腐蚀与防护网http://www.ecorr.org
责任编辑:殷鹏飞
投稿联系:编辑部
电话:010-62313558-806
中国腐蚀与防护网官方 QQ群:140808414
免责声明:本网站所转载的文字、图片与视频资料版权归原创作者所有,如果涉及侵权,请第一时间联系本网删除。
相关文章
官方微信
《腐蚀与防护网电子期刊》征订启事
- 投稿联系:编辑部
- 电话:010-62316606
- 邮箱:fsfhzy666@163.com
- 腐蚀与防护网官方QQ群:140808415
点击排行
PPT新闻
“海洋金属”——钛合金在舰船的
点击数:12048
腐蚀与“海上丝绸之路”
点击数:9763



